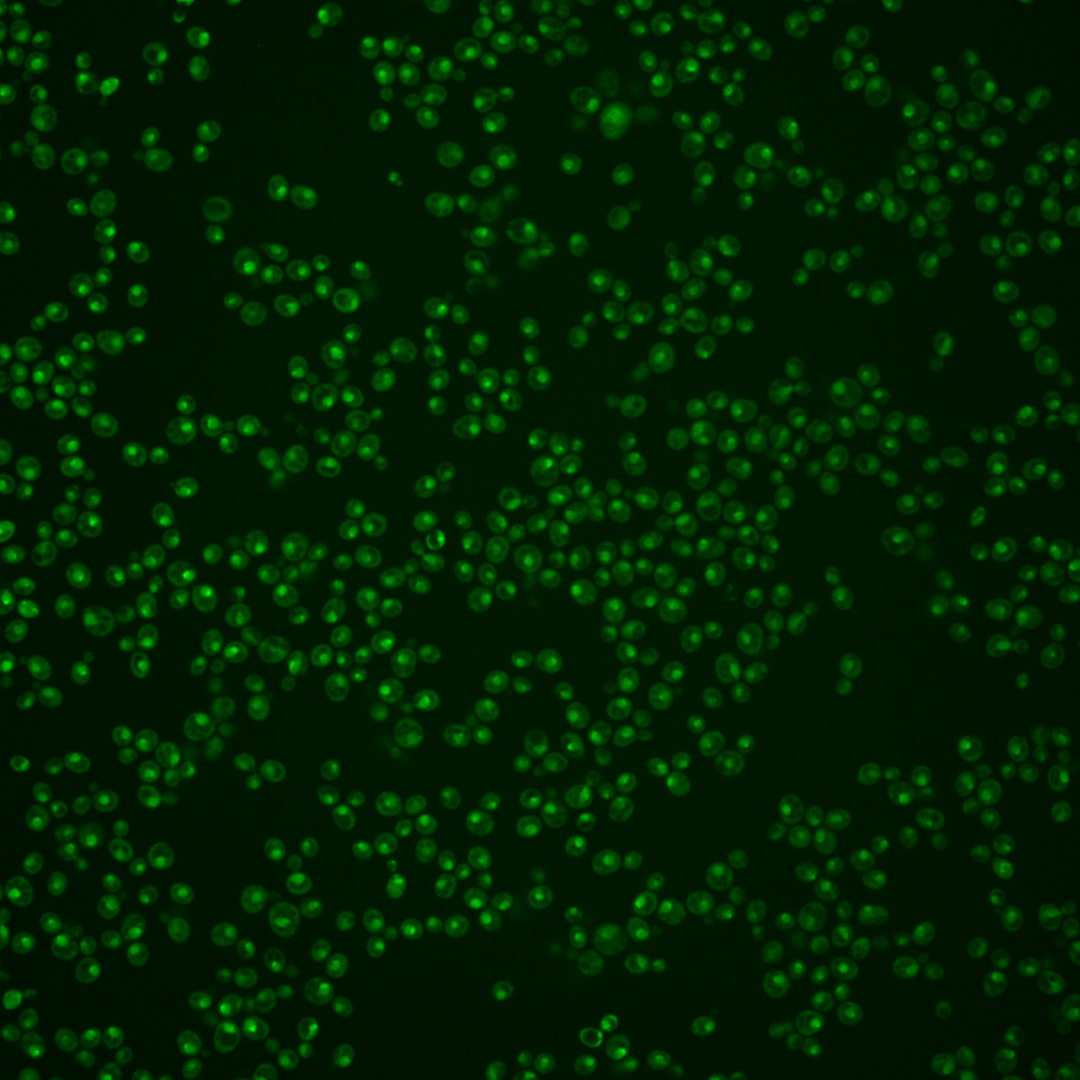
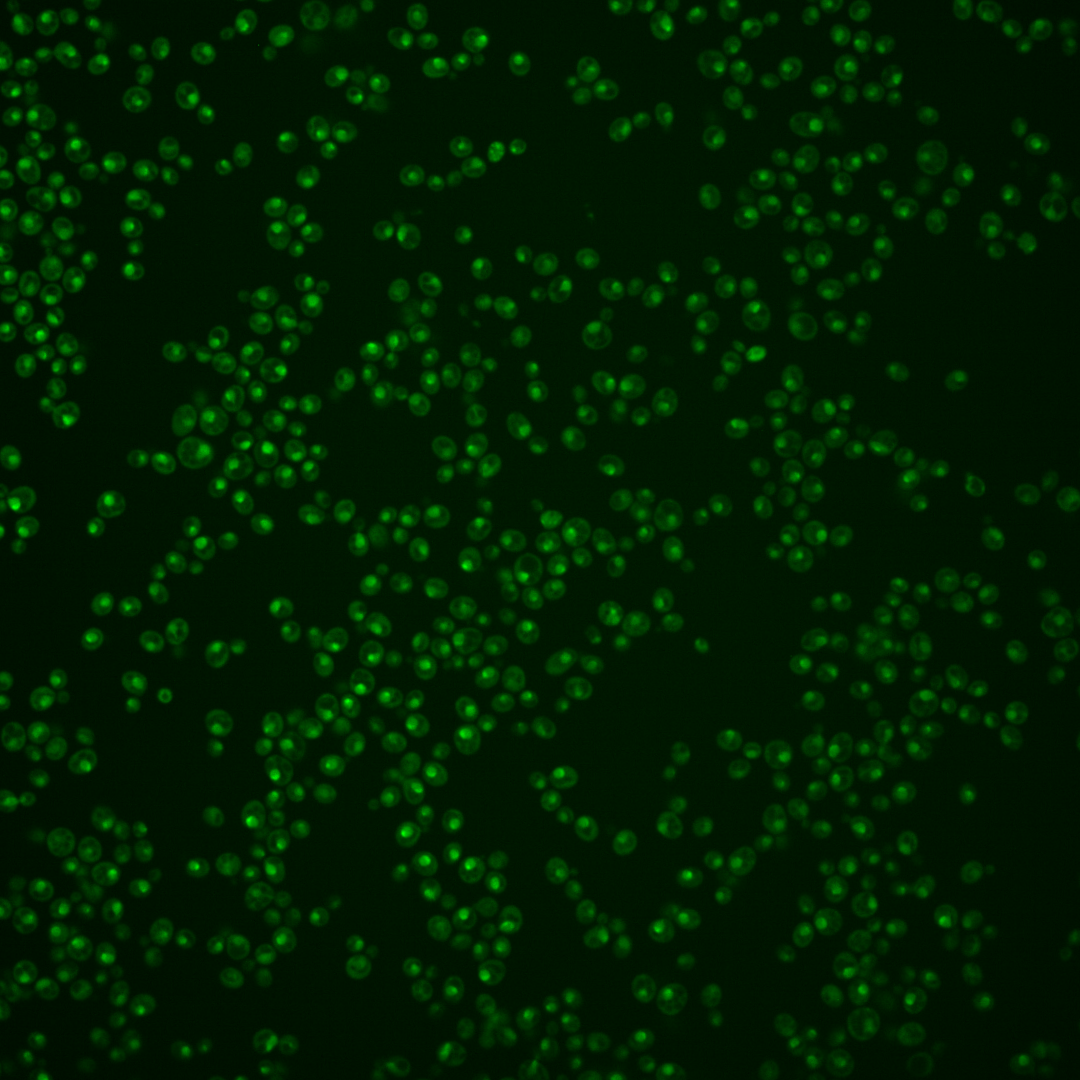
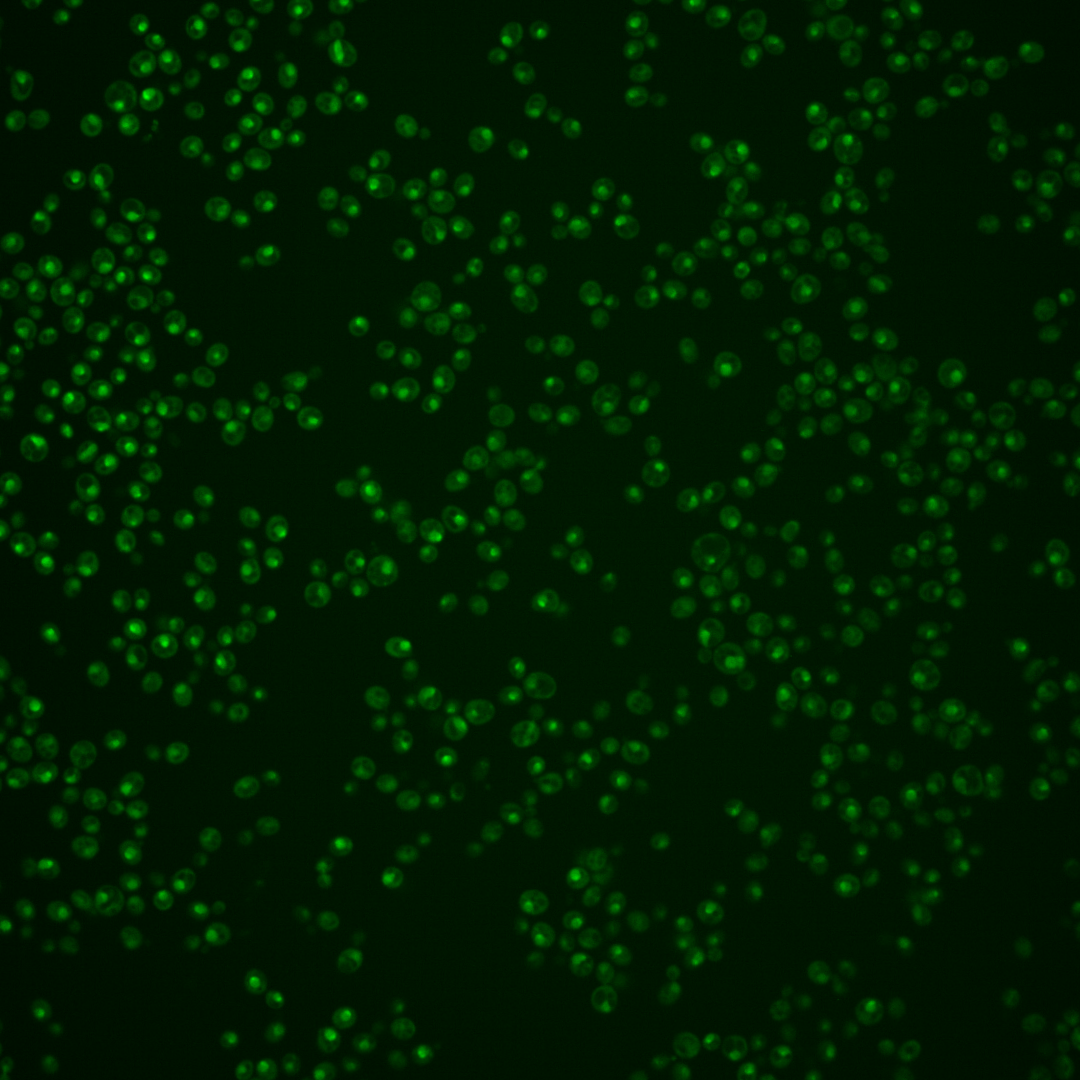
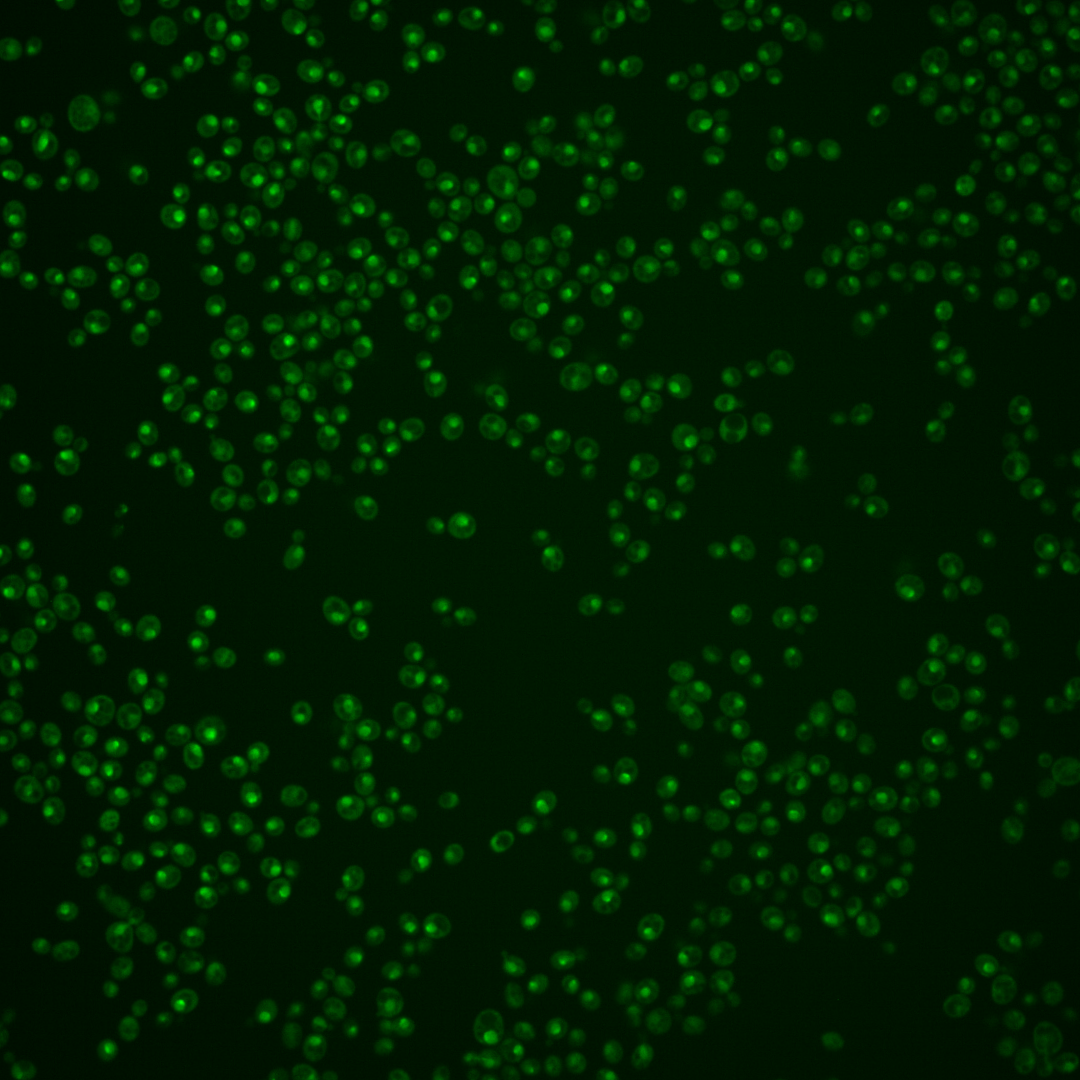

| Standard name | |
|---|---|
| Human Ortholog | |
| Description | Zinc knuckle protein; involved in nuclear RNA processing and degradation as a component of the TRAMP complex; stimulates the poly(A) polymerase activity of Pap2p in vitro; AIR1 has a paralog, AIR2, that arose from the whole genome duplication; although Air1p and Air2p are homologous TRAMP subunits, they have nonredundant roles in regulation of substrate specificity of the exosome |
Micrographs




















































































Sub-cellular Localization
Yeast GFP Assignment
Protein Abundance
Localization Change
External localization resources
| ensLOC | DeepLoc | |||||||||||||||||||||||
|---|---|---|---|---|---|---|---|---|---|---|---|---|---|---|---|---|---|---|---|---|---|---|---|---|
| Localization | WT1 | WT2 | WT3 | RAP60 | RAP140 | RAP220 | RAP300 | RAP380 | RAP460 | RAP540 | RAP620 | RAP700 | HU80 | HU120 | HU160 | rpd3Δ_1 | rpd3Δ_2 | rpd3Δ_3 | WT1 | WT2 | WT3 | AF100 | AF140 | AF180 |
| Cortical Patches | 0 | 0 | 0 | 0 | 0 | 0 | 0 | 0 | 0 | 0 | 0 | 1 | 0 | 0 | 0 | 0 | 0 | 0 | 2 | 0 | 0 | 1 | 0 | 0 |
| Bud | 0 | 1 | 0 | 1 | 3 | 1 | 6 | 12 | 9 | 15 | 14 | 14 | 0 | 0 | 0 | 0 | 0 | 0 | 3 | 0 | 0 | 2 | 5 | 5 |
| Bud Neck | 0 | 0 | 0 | 2 | 2 | 4 | 2 | 1 | 3 | 5 | 0 | 6 | 1 | 1 | 1 | 0 | 0 | 0 | 1 | 0 | 0 | 2 | 3 | 8 |
| Bud Site | 1 | 0 | 0 | 2 | 2 | 4 | 5 | 3 | 11 | 19 | 14 | 10 | 0 | 0 | 0 | 0 | 0 | 0 | – | – | – | – | – | – |
| Cell Periphery | 0 | 0 | 0 | 0 | 0 | 0 | 0 | 0 | 0 | 0 | 0 | 1 | 1 | 1 | 0 | 0 | 0 | 0 | 0 | 0 | 0 | 0 | 0 | 0 |
| Cytoplasm | 7 | 3 | 1 | 23 | 53 | 65 | 134 | 110 | 142 | 186 | 123 | 146 | 14 | 43 | 78 | 1 | 2 | 15 | 1 | 2 | 0 | 1 | 4 | 8 |
| Endoplasmic Reticulum | 1 | 0 | 0 | 1 | 0 | 1 | 0 | 0 | 0 | 0 | 0 | 0 | 0 | 0 | 0 | 2 | 1 | 2 | 0 | 0 | 0 | 1 | 2 | 0 |
| Endosome | 0 | 0 | 0 | 19 | 23 | 8 | 9 | 3 | 8 | 4 | 1 | 2 | 10 | 35 | 75 | 2 | 0 | 1 | 13 | 3 | 3 | 5 | 42 | 59 |
| Golgi | 0 | 0 | 0 | 0 | 0 | 0 | 0 | 0 | 0 | 0 | 0 | 0 | 0 | 1 | 0 | 0 | 0 | 0 | 2 | 0 | 0 | 1 | 0 | 1 |
| Mitochondria | 48 | 5 | 2 | 29 | 35 | 126 | 346 | 260 | 321 | 391 | 367 | 280 | 3 | 2 | 1 | 0 | 1 | 5 | 6 | 0 | 0 | 1 | 6 | 13 |
| Nucleus | 114 | 21 | 18 | 190 | 399 | 222 | 232 | 161 | 153 | 166 | 132 | 130 | 188 | 203 | 195 | 18 | 13 | 55 | 94 | 44 | 38 | 73 | 100 | 62 |
| Nuclear Periphery | 0 | 0 | 0 | 0 | 0 | 0 | 0 | 1 | 1 | 3 | 1 | 2 | 0 | 0 | 0 | 0 | 0 | 0 | 1 | 0 | 1 | 1 | 2 | 4 |
| Nucleolus | 43 | 16 | 2 | 69 | 15 | 3 | 6 | 7 | 3 | 1 | 3 | 1 | 44 | 103 | 151 | 9 | 5 | 7 | 61 | 18 | 9 | 42 | 81 | 78 |
| Peroxisomes | 0 | 0 | 0 | 0 | 0 | 1 | 0 | 0 | 0 | 0 | 0 | 0 | 0 | 1 | 0 | 0 | 0 | 0 | 0 | 0 | 0 | 0 | 0 | 1 |
| SpindlePole | 1 | 1 | 0 | 75 | 53 | 15 | 23 | 20 | 21 | 19 | 19 | 22 | 20 | 104 | 126 | 1 | 0 | 2 | 12 | 3 | 8 | 6 | 55 | 54 |
| Vac/Vac Membrane | 11 | 5 | 0 | 5 | 50 | 37 | 39 | 19 | 20 | 33 | 21 | 19 | 8 | 4 | 9 | 9 | 2 | 14 | 13 | 6 | 11 | 25 | 72 | 65 |
| Unique Cell Count | 184 | 45 | 22 | 321 | 572 | 402 | 634 | 480 | 539 | 655 | 505 | 495 | 257 | 388 | 480 | 38 | 20 | 92 | 219 | 82 | 78 | 170 | 385 | 379 |
| Labelled Cell Count | 226 | 52 | 23 | 416 | 635 | 487 | 802 | 597 | 692 | 842 | 695 | 634 | 289 | 498 | 636 | 42 | 24 | 101 | 219 | 82 | 78 | 170 | 385 | 379 |
Yeast GFP Assignment
Protein Abundance
| Screen | WT1 | WT2 | WT3 | RAP60 | RAP140 | RAP220 | RAP300 | RAP380 | RAP460 | RAP540 | RAP620 | RAP700 | HU80 | HU120 | HU160 | rpd3Δ_1 | rpd3Δ_2 | rpd3Δ_3 | AF100 | AF140 | AF180 |
|---|---|---|---|---|---|---|---|---|---|---|---|---|---|---|---|---|---|---|---|---|---|
| Mean Cell GFP Intensity (1e-4) | 4.8 | 5.3 | 5.4 | 6.0 | 5.6 | 4.4 | 3.9 | 4.2 | 3.8 | 3.8 | 3.5 | 3.8 | 6.9 | 6.8 | 6.4 | 8.4 | 7.4 | 8.5 | 6.2 | 6.5 | 6.5 |
| Std Deviation (1e-4) | 0.9 | 0.9 | 1.4 | 1.3 | 1.2 | 1.3 | 1.1 | 1.4 | 1.7 | 2.0 | 1.7 | 1.4 | 1.0 | 1.2 | 1.3 | 1.6 | 1.3 | 1.6 | 1.7 | 1.2 | 1.1 |
| Intensity Change (Log2) | – | – | – | 0.15 | 0.05 | -0.3 | -0.46 | -0.38 | -0.52 | -0.5 | -0.62 | -0.53 | 0.34 | 0.32 | 0.24 | 0.63 | 0.44 | 0.64 | 0.2 | 0.26 | 0.27 |
Localization Change
| Localization | RAP60 | RAP140 | RAP220 | RAP300 | RAP380 | RAP460 | RAP540 | RAP620 | RAP700 | HU80 | HU120 | HU160 | rpd3Δ_1 | rpd3Δ_2 | rpd3Δ_3 |
|---|---|---|---|---|---|---|---|---|---|---|---|---|---|---|---|
| Cortical Patches | 0 | 0 | 0 | 0 | 0 | 0 | 0 | 0 | 0 | 0 | 0 | 0 | 0 | 0 | 0 |
| Bud | 0 | 0 | 0 | 0 | 0 | 0 | 0 | 0 | 0 | 0 | 0 | 0 | 0 | 0 | 0 |
| Bud Neck | 0 | 0 | 0 | 0 | 0 | 0 | 0 | 0 | 0 | 0 | 0 | 0 | 0 | 0 | 0 |
| Bud Site | 0 | 0 | 0 | 0 | 0 | 0 | 0 | 0 | 0 | 0 | 0 | 0 | 0 | 0 | 0 |
| Cell Periphery | 0 | 0 | 0 | 0 | 0 | 0 | 0 | 0 | 0 | 0 | 0 | 0 | 0 | 0 | 0 |
| Cytoplasm | 0 | 0 | 0 | 0 | 0 | 2.3 | 2.5 | 2.1 | 2.5 | 0 | 0 | 0 | 0 | 0 | 0 |
| Endoplasmic Reticulum | 0 | 0 | 0 | 0 | 0 | 0 | 0 | 0 | 0 | 0 | 0 | 0 | 0 | 0 | 0 |
| Endosome | 0 | 0 | 0 | 0 | 0 | 0 | 0 | 0 | 0 | 0 | 0 | 0 | 0 | 0 | 0 |
| Golgi | 0 | 0 | 0 | 0 | 0 | 0 | 0 | 0 | 0 | 0 | 0 | 0 | 0 | 0 | 0 |
| Mitochondria | 0 | 0 | 0 | 0 | 0 | 0 | 0 | 0 | 0 | 0 | 0 | 0 | 0 | 0 | 0 |
| Nucleus | -2.1 | -1.2 | -2.5 | -4.3 | -4.6 | -5.3 | -5.9 | -5.7 | -5.6 | -0.9 | -2.7 | -3.8 | -2.6 | -1.2 | -1.9 |
| Nuclear Periphery | 0 | 0 | 0 | 0 | 0 | 0 | 0 | 0 | 0 | 0 | 0 | 0 | 0 | 0 | 0 |
| Nucleolus | 0 | 0 | 0 | 0 | 0 | 0 | 0 | 0 | 0 | 0 | 1.8 | 2.2 | 0 | 0 | 0 |
| Peroxisomes | 0 | 0 | 0 | 0 | 0 | 0 | 0 | 0 | 0 | 0 | 0 | 0 | 0 | 0 | 0 |
| SpindlePole | 0 | 0 | 0 | 0 | 0 | 0 | 0 | 0 | 0 | 0 | 2.8 | 2.8 | 0 | 0 | 0 |
| Vacuole | 0 | 0 | 0 | 0 | 0 | 0 | 0 | 0 | 0 | 0 | 0 | 0 | 0 | 0 | 0 |
External localization resources
Images






























Protein Concentration and Protein Localization Data
| R1 | R2 | R3 | ||||||||||||||||
|---|---|---|---|---|---|---|---|---|---|---|---|---|---|---|---|---|---|---|
| G1 Pre-START | G1 Post-START | S/G2 | Metaphase | Anaphase | Telophase | G1 Pre-START | G1 Post-START | S/G2 | Metaphase | Anaphase | Telophase | G1 Pre-START | G1 Post-START | S/G2 | Metaphase | Anaphase | Telophase | |
| Concentration | 3.3511 | 3.7704 | 3.4862 | 3.1919 | 2.9642 | 3.4558 | 1.6834 | 2.5934 | 2.1995 | 1.4428 | 2.1314 | 2.0553 | 1.6292 | 2.2805 | 1.5905 | 1.9247 | 1.3813 | 1.3155 |
| Actin | 0.0032 | 0 | 0.0008 | 0.0002 | 0.0004 | 0.001 | 0.009 | 0.0001 | 0.007 | 0.0361 | 0.0022 | 0.0002 | 0.0218 | 0 | 0.0009 | 0.0007 | 0.0014 | 0.0003 |
| Bud | 0.0002 | 0.0001 | 0.0002 | 0.0001 | 0.0002 | 0.0001 | 0.0003 | 0.0002 | 0.0003 | 0.0005 | 0.0001 | 0.0001 | 0.0009 | 0.0008 | 0.0003 | 0.0008 | 0.0005 | 0.0002 |
| Bud Neck | 0.0023 | 0.0013 | 0.0023 | 0.0017 | 0.0043 | 0.0046 | 0.003 | 0.0015 | 0.0018 | 0.0159 | 0.0007 | 0.0044 | 0.0031 | 0.0028 | 0.0022 | 0.0089 | 0.0025 | 0.0077 |
| Bud Periphery | 0.0004 | 0.0002 | 0.0004 | 0.0002 | 0.0004 | 0.0003 | 0.0007 | 0.0005 | 0.0007 | 0.0018 | 0.0002 | 0.0004 | 0.0015 | 0.0012 | 0.0006 | 0.0012 | 0.0014 | 0.0007 |
| Bud Site | 0.0016 | 0.0023 | 0.0015 | 0.0007 | 0.001 | 0.0005 | 0.0017 | 0.0023 | 0.002 | 0.0018 | 0.0012 | 0.0007 | 0.0117 | 0.0022 | 0.0047 | 0.0218 | 0.0023 | 0.0011 |
| Cell Periphery | 0.0005 | 0.0002 | 0.0003 | 0.0001 | 0.0001 | 0.0002 | 0.0003 | 0.0003 | 0.0003 | 0.0005 | 0.0001 | 0.0002 | 0.0006 | 0.0008 | 0.0006 | 0.001 | 0.0004 | 0.0005 |
| Cytoplasm | 0.0022 | 0.0006 | 0.0007 | 0.0008 | 0.0013 | 0.0004 | 0.0008 | 0.0032 | 0.0011 | 0.0002 | 0.0004 | 0.0018 | 0.0093 | 0.001 | 0.0017 | 0.0006 | 0.0006 | 0.0005 |
| Cytoplasmic Foci | 0.0068 | 0.0006 | 0.0018 | 0.0004 | 0.0012 | 0.0003 | 0.013 | 0.0035 | 0.0043 | 0.0066 | 0.0136 | 0.0003 | 0.0136 | 0.0004 | 0.0044 | 0.0086 | 0.0078 | 0.0009 |
| Eisosomes | 0.0001 | 0 | 0 | 0 | 0 | 0 | 0.0001 | 0 | 0.0001 | 0.0001 | 0 | 0 | 0.0015 | 0 | 0 | 0 | 0.0001 | 0 |
| Endoplasmic Reticulum | 0.0013 | 0.0004 | 0.0001 | 0.0001 | 0.0005 | 0.0003 | 0.0004 | 0.0004 | 0.0007 | 0.0001 | 0.0007 | 0.0025 | 0.0017 | 0.0002 | 0.0003 | 0.0002 | 0.0002 | 0.0001 |
| Endosome | 0.0074 | 0.0023 | 0.0038 | 0.0005 | 0.0047 | 0.0018 | 0.0097 | 0.0033 | 0.0091 | 0.0048 | 0.006 | 0.0048 | 0.0213 | 0.0009 | 0.0093 | 0.003 | 0.0423 | 0.003 |
| Golgi | 0.0017 | 0.0002 | 0.0012 | 0.0001 | 0.0005 | 0.0004 | 0.0035 | 0.0003 | 0.0018 | 0.0089 | 0.0053 | 0.0003 | 0.0099 | 0.0001 | 0.0034 | 0.0021 | 0.011 | 0.0022 |
| Lipid Particles | 0.0106 | 0.0054 | 0.0034 | 0.0005 | 0.0027 | 0.0009 | 0.0168 | 0.0039 | 0.0071 | 0.0682 | 0.036 | 0.0006 | 0.015 | 0.0019 | 0.0069 | 0.0049 | 0.022 | 0.0007 |
| Mitochondria | 0.0046 | 0.0002 | 0.0005 | 0.0003 | 0.0006 | 0.0016 | 0.0025 | 0.0004 | 0.0059 | 0.0033 | 0.0022 | 0.0004 | 0.0224 | 0.0003 | 0.0098 | 0.0012 | 0.0775 | 0.0058 |
| None | 0.0032 | 0.0003 | 0.0003 | 0.0005 | 0.0006 | 0.0008 | 0.0005 | 0.0008 | 0.0017 | 0.0002 | 0.0003 | 0.001 | 0.0101 | 0.0001 | 0.0008 | 0.0002 | 0.0003 | 0.0001 |
| Nuclear Periphery | 0.0113 | 0.0055 | 0.0032 | 0.0041 | 0.036 | 0.0037 | 0.0033 | 0.0079 | 0.006 | 0.0008 | 0.0809 | 0.0039 | 0.0078 | 0.0039 | 0.0047 | 0.0024 | 0.014 | 0.0081 |
| Nucleolus | 0.4339 | 0.5232 | 0.615 | 0.5444 | 0.3407 | 0.4925 | 0.36 | 0.3307 | 0.4901 | 0.3552 | 0.1908 | 0.3836 | 0.3492 | 0.3783 | 0.5556 | 0.4143 | 0.1537 | 0.4106 |
| Nucleus | 0.4534 | 0.4366 | 0.3471 | 0.399 | 0.543 | 0.4664 | 0.5418 | 0.6172 | 0.4423 | 0.4755 | 0.6302 | 0.5849 | 0.4498 | 0.587 | 0.3714 | 0.5114 | 0.6426 | 0.5388 |
| Peroxisomes | 0.0099 | 0.0001 | 0.0005 | 0.0001 | 0.0005 | 0.0002 | 0.0065 | 0.0004 | 0.0014 | 0.0131 | 0.0227 | 0.0001 | 0.0172 | 0.0001 | 0.0065 | 0.0047 | 0.0026 | 0.0005 |
| Punctate Nuclear | 0.0424 | 0.015 | 0.0134 | 0.0456 | 0.0586 | 0.022 | 0.0197 | 0.0171 | 0.0114 | 0.0041 | 0.0043 | 0.0077 | 0.0176 | 0.0034 | 0.0073 | 0.0023 | 0.0083 | 0.014 |
| Vacuole | 0.0021 | 0.0049 | 0.003 | 0.0005 | 0.0019 | 0.0015 | 0.0055 | 0.0048 | 0.0035 | 0.0019 | 0.0007 | 0.0019 | 0.0103 | 0.0118 | 0.0072 | 0.0085 | 0.0052 | 0.0035 |
| Vacuole Periphery | 0.001 | 0.0005 | 0.0003 | 0.0001 | 0.0008 | 0.0004 | 0.0008 | 0.0011 | 0.0014 | 0.0004 | 0.0013 | 0.0003 | 0.0037 | 0.0027 | 0.0012 | 0.0012 | 0.0032 | 0.0005 |
Sequencing Data
| R1 | R2 | |||||||||
|---|---|---|---|---|---|---|---|---|---|---|
| G1 Post-START | S/G2 | Metaphase | Anaphase | Telophase | G1 Post-START | S/G2 | Metaphase | Anaphase | Telophase | |
| Gene Expression | 23.9428 | 22.7695 | 25.006 | 20.9155 | 26.4194 | 20.3655 | 19.1085 | 15.2277 | 14.7619 | 23.075 |
| Translational Efficiency | 1.8091 | 1.7065 | 1.2098 | 1.1519 | 1.336 | 1.3158 | 1.2697 | 1.2102 | 1.4135 | 1.3211 |
Hit Data
| Dataset | Hit |
|---|---|
| Protein Concentration | ✘ |
| Protein Localization | ✘ |
| Gene Expression | ✘ |
| Translational Efficiency | ✘ |
Endocytosis
| Temp | Actin Patch (Sac6-tdTomato) | Cortical Patch (Sla1-GFP) | Late Endosome (Snf7-GFP) | Vacuole (Vph1-GFP) |
|---|---|---|---|---|
| 37℃ | ||||
| RT |
Cell Cycle Omics
CYCLoPs (Air1-GFP)
| Gene / Allele | Actin Patch (Sac6-tdTomato) | Cortical Patch (Sla1-GFP) | Late Endosome (Snf7-GFP) | Vacuole (Sac6-tdTomato) |
|---|
| Gene | Images |
|---|
| Gene | Images |
|---|
Images are not yet available
Images are not yet available